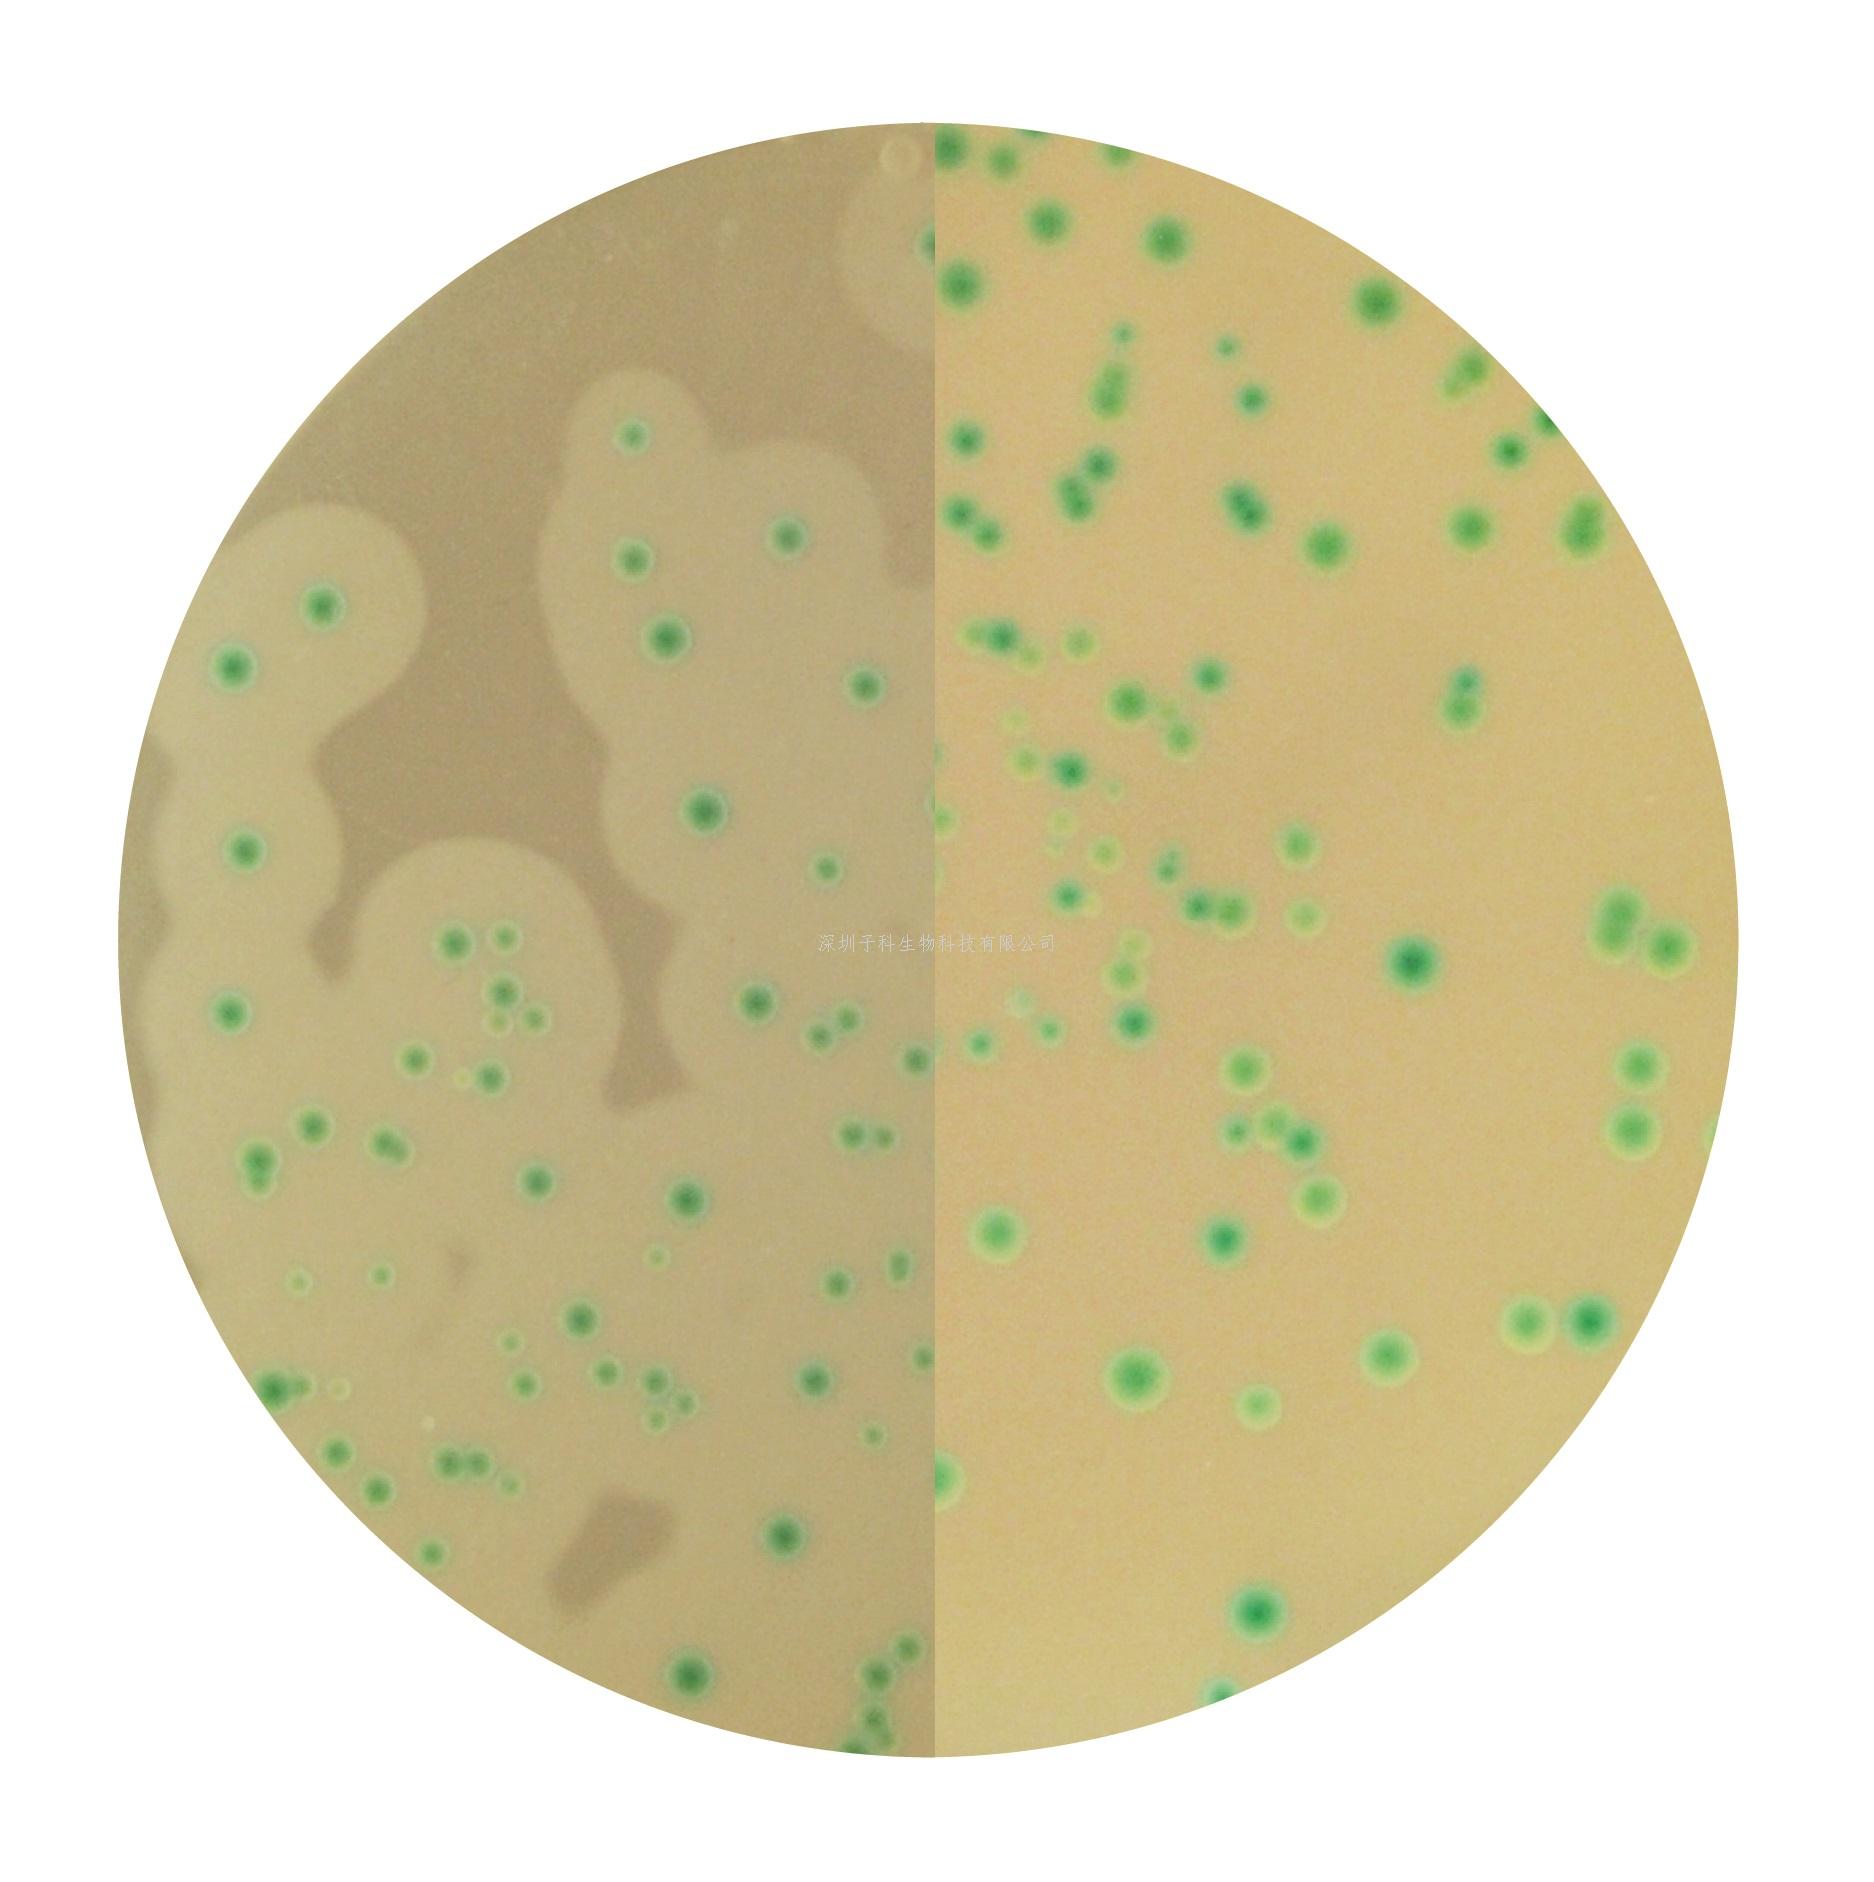

热门关键词: ELISA试剂盒 - 大鼠ELISA试剂盒- 小鼠ELISA试剂盒
全国统一客服热线:
0755-28715175
热门关键词: ELISA试剂盒 - 大鼠ELISA试剂盒- 小鼠ELISA试剂盒
全国统一客服热线:
0755-28715175

货品名称:李斯特菌显色培养基 Listeria Chromogenic Agar Base according to Ottaviani and Agosti (ALOA) ISO 货号:1345 规格:71g/L 应用:用于检测和计数单核细胞增生李斯特菌的选择性培养基。 |
组分 g/L:酪蛋白酶水解物6g/L; 琼脂15g/L; 氯化钠5g/L; 丙酮酸钠2g/L; 消化酶18g/L; 甘油磷酸镁 1g/L; 葡萄糖 2g/L; 硫酸镁0.5g/L; 硫酸氢钠2.5g/L; 酵母膏和氯化锂10g/L; 5-溴-4-氯-3-吲哚-D-葡萄糖吡喃苷0.05g/L
PH值:7.2±0.2
操作步骤:
1、取瓶内干粉71g,溶于1000ml去离子水的洁净三角瓶中。
2、缓慢加热,不停搅拌,使其完全溶解。将溶解完全的培养基高压灭菌(121ºC,15min)。
3、加热后的培养基冷却至55ºC,添加李斯特增补剂01(24毫升/瓶,货号6031)并强烈摇晃使其混合均匀。
4、再次添加李斯特增补剂02(3g/冻干小瓶,货号6040),取6ml去离子水注入此增补剂中,溶解后加入。
5、摇晃均匀,倾注平皿,使其凝固,晾干备用。
保存:该成品平板在室温可保存一天或在冰箱内储存2周(2-8ºC,避光)
接种:划线或涂布接种(冰箱内保存的平板使用前应恢复至室温)
培养:( 37±1 ºC/48±4 h, 48-72h菌落最佳)
结果:
微生物(Microorganisms)
| 生长情况
| 菌落颜色 |
单核细胞增生李斯特菌4b ATCC®13932 | 生长良好 | 蓝绿色,带有白色光晕 |
单核细胞增生李斯特菌1/2a ATCC®33090 | 生长良好 | 蓝绿色,带有白色光晕 |
英诺克李斯特菌ATCC®33090 | 生长良好 | 蓝绿色,无白色光晕 |
其他微生物 |
| (抑制,无色) |
微生物检验:根据ISO 11133,培养条件:( 37±1 ºC / 48±4 h)。接种条件:定性(10^3-10^4 CFU)/选择性(10^4-10^6 CFU)/特异性(10^3-10^4 CFU)。参考培养基:TSA。
贮存条件:干粉需保存于15-25ºC,在有效期前使用。
污染处理:使用过的培养基需要在121ºC灭菌至少20分钟才可以按照有关规定丢弃。
附:供体外诊断使用,产品需专业人员操作。
0755-28715175/33164177

粤公网安备 44030902000304号